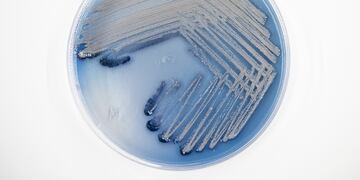

Luego de las lluvias que se produjeron durante los últimos días en toda la región, el Dique San Roque recibió una buena cantidad de agua producto de las precipitaciones y de las crecidas de sus afluentes.
Según la última medición, realizada por Secretaría de Recursos Hídricos de la provincia de Córdoba, el nivel actual del lago es de 35,3 metros, alcanzando su vertedero.
En este sentido, el incremento en los caudales de los ríos San Antonio y Cosquín, así como en los arroyos Las Mojarras y Los Chorrillos, produjeron que el nivel de agua del lago San Roque aumente más de dos metros en los últimos días.

Luego de un largo periodo, en el cual el dique se mostraba muy por debajo de su caudal habitual para la época estival, lució repleto y según los registros históricos estaría en su nivel más alto de este 2023.